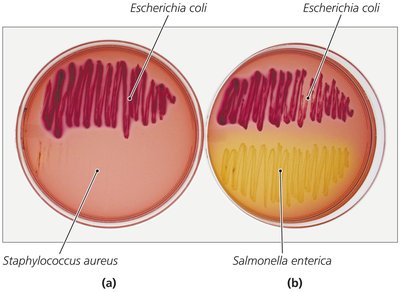
The Use of Macconkey Agar
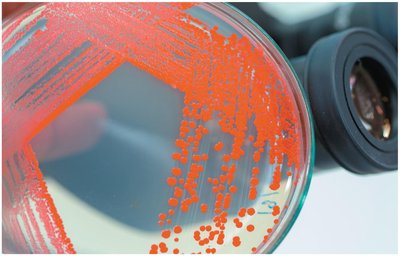
Red Colonies of Serratia Marcescens

BackPathogenic Gram-Negative Cocci and Bacilli: Structure, Pathogenesis, and Clinical Relevance
Study Guide - Smart Notes
Tailored notes based on your materials, expanded with key definitions, examples, and context.
Gram-Negative Bacteria: Overview
General Characteristics and Clinical Importance
Gram-negative bacteria represent the largest group of human bacterial pathogens, primarily due to the presence of lipid A (endotoxin) in their cell wall. Lipid A is responsible for triggering severe immune responses, including fever, vasodilation, inflammation, shock, and disseminated intravascular coagulation (DIC). Most Gram-negative bacteria that breach the skin or mucous membranes, grow at 37°C, and evade the immune system can cause disease in humans.

Lipid A (Endotoxin): Triggers cytokine release, blood-clotting reactions, and complement activation, leading to fever, inflammation, shock, and DIC.
Clinical Relevance: Gram-negative infections are often severe due to these systemic effects.
Pathogenic Gram-Negative Cocci: Neisseria
Structure and Physiology
Neisseria is the only genus of Gram-negative cocci that regularly causes disease in humans. These bacteria are aerobic, nonmotile, and typically arranged as diplococci. They are oxidase positive, which distinguishes them from many other Gram-negative pathogens. Pathogenic strains possess fimbriae, a polysaccharide capsule, and a cell wall containing lipid A. Two species are pathogenic to humans: N. gonorrhoeae and N. meningitidis.

Key Features: Diplococci arrangement, oxidase positive, presence of fimbriae and capsule.
The Gonococcus: Neisseria gonorrhoeae
N. gonorrhoeae causes gonorrhea, a sexually transmitted disease that only occurs in humans. The risk of infection increases with the number of sexual encounters, and most cases in the United States occur in adolescents. Gonorrhea is more common in females, often asymptomatic, but can lead to pelvic inflammatory disease. In men, it causes painful urination and pus-filled discharge. Infections can also occur outside the reproductive tract, including proctitis, pharyngitis, gingivitis, and neonatal eye infections during childbirth.

Immune Evasion: Secretes protease that cleaves secretory IgA and survives within neutrophils.
Diagnosis: Genetic probes for asymptomatic cases; Gram-negative diplococci in pus for symptomatic men.
Treatment: Complicated by resistant strains; broad-spectrum intramuscular cephalosporins are used.
Prevention: Sexual abstinence, monogamy, proper condom use, and antimicrobials for newborns' eyes.
The Meningococcus: Neisseria meningitidis
N. meningitidis is the most common cause of meningitis in individuals under 20 years of age and can be part of the normal microbiota of the upper respiratory tract. Transmission occurs via respiratory droplets, especially among people in close contact. Meningitis can cause death within hours, and meningococcal septicemia is also life-threatening, often presenting with petechiae (small hemorrhagic lesions).

Diagnosis: Rapid identification of Gram-negative diplococci in CNS phagocytes is critical.
Treatment: Immediate administration of antimicrobials such as ceftriaxone.
Prevention: Vaccination against some strains; eradication is difficult due to asymptomatic carriers.
Pathogenic, Gram-Negative, Facultatively Anaerobic Bacilli
Families and Clinical Relevance
Most human pathogens in this group belong to the Enterobacteriaceae and Pasteurellaceae families. The oxidase test distinguishes between these families. These bacteria are significant causes of healthcare-associated infections.

Enterobacteriaceae: Intestinal microbiota, ubiquitous in water, soil, and decaying vegetation; most common Gram-negative pathogens in humans.
Pasteurellaceae: Require heme or cytochromes for growth; includes Pasteurella and Haemophilus.
Structure and Physiology of Enterobacteriaceae
Members are motile bacilli and coccobacilli, reduce nitrate to nitrite, and ferment glucose. They grow best in aerobic environments and are distinguished by biochemical properties, motility, and colony characteristics.

Antigenic Components: Membrane, protein, and polysaccharide capsular antigens used for strain/species identification.
Virulence Factors: Fimbriae, exotoxins, adhesins, and type III secretion systems.

Diagnosis, Treatment, and Prevention
Diagnosis: Detection in urine, blood, or cerebrospinal fluid; rapid biochemical tests.
Treatment: Diarrhea is usually self-limited; internal infections require antimicrobials.
Prevention: Good hygiene and proper sewage control.
Classification of Pathogenic Enterobacteriaceae
Coliforms: Rapidly ferment lactose; normal microbiota but may be opportunistic pathogens.
Noncoliform Opportunists: Do not ferment lactose.
True Pathogens: Always pathogenic due to numerous virulence factors.
Coliform Opportunistic Enterobacteriaceae
Escherichia coli: Most common and important coliform; causes gastroenteritis, pediatric diarrhea, and urinary tract infections. Virulent strains have plasmids for fimbriae, adhesins, and exotoxins. E. coli O157:H7 is associated with hemorrhagic colitis and hemolytic uremic syndrome, often from undercooked beef or contaminated produce.
Klebsiella: Found in digestive and respiratory systems; capsule protects from phagocytosis. K. pneumoniae causes pneumonia, bacteremia, meningitis, wound infections, and UTIs.
Serratia: Produces red pigment at room temperature; grows on hospital supplies; causes opportunistic infections in immunocompromised patients; often drug-resistant.
Enterobacter, Hafnia, Citrobacter: Found in soil, water, and digestive tracts; cause healthcare-associated infections; often drug-resistant.
Noncoliform Opportunistic Enterobacteriaceae
Proteus: Facultative anaerobe; P. mirabilis is associated with UTIs in catheterized patients and can cause kidney stones; highly drug-resistant.
Morganella, Providencia, Edwardsiella: Cause healthcare-associated UTIs; Providencia may cause kidney stones.

Truly Pathogenic Enterobacteriaceae
Salmonella: Motile, peritrichous bacilli; cause salmonellosis and typhoid fever. Human infection usually from contaminated food, especially poultry and eggs. S. enterica serotype Typhi causes typhoid fever, which can be fatal if untreated.
Shigella: Nonmotile, oxidase-negative; causes shigellosis (severe dysentery). S. sonnei is predominant in industrialized nations; S. flexneri in developing countries. S. dysenteriae produces Shiga toxin, which inhibits protein synthesis in host cells.
Yersinia: Three species are important: Y. enterocolitica (intestinal inflammation), Y. pseudotuberculosis (milder intestinal disease), and Y. pestis (bubonic and pneumonic plague).

The Pasteurellaceae
Pasteurella
Normal microbiota in animals' oral and nasopharyngeal cavities; human infection via animal bites or aerosols. Most cases are localized, but widespread infection can occur in immunosuppressed individuals. Treated effectively with antibacterial drugs.
Haemophilus
Small, pleomorphic bacilli requiring heme and NAD+ for growth. Colonize mucous membranes; some species cause opportunistic infections. H. ducreyi causes a sexually transmitted disease. H. influenzae type b (Hib) was a common cause of meningitis before vaccination; the Hib vaccine has greatly reduced disease incidence.

Pathogenic, Gram-Negative, Aerobic Bacilli
Bartonella
B. bacilliformis: Causes bartonellosis, transmitted by sand flies; endemic in parts of South America.
B. quintana: Causes trench fever, transmitted by body lice; can cause bacillary angiomatosis and peliosis hepatis in immunocompromised patients.
B. henselae: Causes cat-scratch disease, transmitted by cat scratches/bites; common in children.

Brucella
Small, nonmotile, aerobic coccobacilli; B. melitensis causes brucellosis in humans, often mild or asymptomatic. Infection from contaminated dairy or animal contact; characterized by fluctuating fever. Vaccine available for animals.
Bordetella
B. pertussis causes pertussis (whooping cough), especially in children. Disease mediated by adhesins and toxins (pertussis toxin, adenylate cyclase toxin, dermonecrotic toxin, tracheal cytotoxin). Spread by inhalation of aerosols; diagnosis is clinical, treatment is supportive, and prevention is via DTaP/Tdap vaccine.

Burkholderia
B. cepacia: Opportunistic pathogen in cystic fibrosis patients; resistant to many drugs.
B. pseudomallei: Causes melioidosis.
Pseudomonads
Pseudomonas aeruginosa: Ubiquitous, opportunistic pathogen, especially in immunocompromised and cystic fibrosis patients. Produces biofilm and multiple virulence factors; highly drug-resistant.
Moraxella and Acinetobacter
Opportunistic pathogens causing respiratory, urinary, and CNS infections; often hospital-acquired.
Francisella
F. tularensis: Causes tularemia, a zoonotic disease transmitted by ticks, animals, or contaminated materials. Highly infectious; treated with antimicrobials.
Legionella
L. pneumophila: Causes Legionnaires’ disease (pneumonia) and Pontiac fever (milder, nonfatal). Acquired by inhaling aerosols from water sources; diagnosis by antibody staining; treated with fluoroquinolones or azithromycin.
Coxiella
C. burnetii: Causes Q fever, transmitted by inhalation of infective bodies from farm animals or pets. Chronic Q fever can cause endocarditis; treated with long-term antimicrobials.
Pathogenic, Gram-Negative, Anaerobic Bacilli
General Characteristics
These bacteria are predominant microbiota of the gastrointestinal, urinary, reproductive, and lower respiratory tracts. They inhibit pathogen growth, synthesize vitamins, and aid digestion but can cause disease if introduced elsewhere in the body.
Bacteroides
Normal microbiota of the intestinal and upper respiratory tracts. B. fragilis is the most important pathogen, causing abdominal, genital, and wound infections. Treated with metronidazole.
Prevotella
Normal microbiota of urinary, genital, and upper respiratory tracts; differ from Bacteroides in bile sensitivity. Cause sinus, ear, periodontal, gynecological, brain, and abdominal infections. Treated by surgical removal and carbapenem.